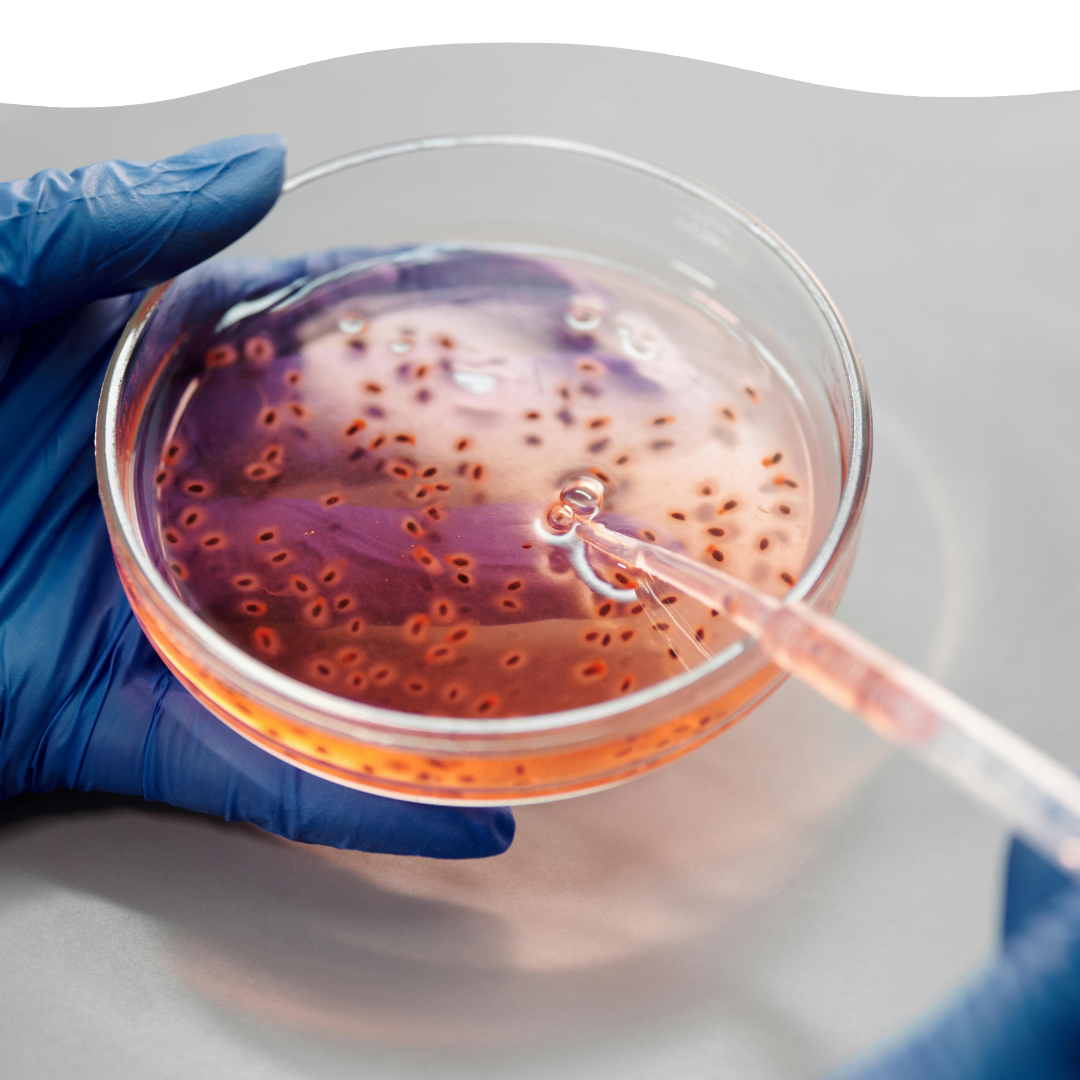

Ho un cane che distrugge tutto in pochi minuti, ma questo pupazzo è ancora perfetto dopo giorni di morsi e tira e molla! Si vede che è fatto con materiali di qualità, finalmente qualcosa che dura davvero, e poi è davvero bello!
Mia sorella ne aveva comprato uno della stessa serie e mi aveva detto che era fantastico, così ho preso anche il cerbiatto per il mio cane. Confermo tutto... bellissimo, super resistente e dolcissimo da vedere!
È fatto così bene che sembra un peluche da tenere sul divano. Ma è anche super resistente, il mio cane lo morde di continuo e non si è rovinato per niente. Ne comprerò un'altro!
Ogni volta resto soddisfatto! Ormai prendo solo questi pupazzi, sono belli, resistenti e il mio cane li adora. Anche il cerbiatto è stupendo, curato nei dettagli e arrivato in pochissimo tempo. Consiglio!!
Ne ho presi diversi di questa linea ma questo è il mio preferito! tenerissimo, ben rifinito e davvero unico. Si vede che è un prodotto di qualità, consigliatissimo!